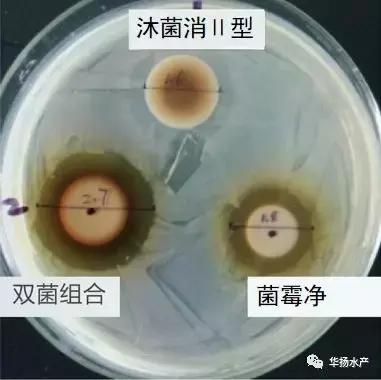
草鱼怎么急救,草鱼身上有伤能自愈吗

针对多地大规模爆发的大草鱼烂身的问题,很多人疑问,为什么越治疗越死亡?是什么怪病吗?
王明闯老师给出了回答,“这不是怪病,如果按照病原性疾病去治疗是没有任何用处的!不管是细菌、虫害、真菌还是病毒,做药敏实验对于该问题的指导意义不大。很多人提到水体环境、气候和管理问题,这也是大而不当的托辞。这个问题其实和‘大草鱼急性烂鳃’原理是一样的,本质上是严重的代谢障碍—拖得越久,死得越惨。鱼死了就什么都没有了。
“我们在养殖终端正全力应对,四川和重庆区域的养殖户配合的比较积极,我提供的方案最终效果还是比较明显,大家要有信心!”
根据今年多地走访治疗,王明闯老师建议,“用药方案其实非常简单,饲料投喂量控制在0.2%以内(全天)一包料50斤,拌入应激宁10包,三黄散10包,制菌灵3包(暂时不建议达克菌),投料机开到最小最慢,一直喂,连续4~5天。”

01 为什么用药这么重?
这样用药的目的是让药物浓度得到极大的提升。鱼在开春这个阶段,肠道的消化吸收功能是奇差无比的,药物浓度不够,吃了也白吃(饲料和常规拌药)。

左图为早春投料后内服保健前的肠道,食物断断续续,不消化;右图为4天强化后的肠道,食物在肠道中是连续的
02 饲料为什么要这么少?
因为虚弱的肠道根本就承受不起什么饲料。我们只需要让鱼每条吃到三五颗高浓度拌药后的饲料就够了。吃的饲料越多,草鱼肠道负担就越重。
03 为什么一定要把投料机开到最慢最小?
因为这与养殖管理的认知是恰好相反的!只有在喂得很慢、很散的情况下,才能保证这么少的饲料被整个鱼群均匀的吃到。
04 鱼不吃饲料怎么办?
鱼群只要不是马上全部死掉,少量的饲料加上缓慢的投喂,鱼群会越聚越多,越来越开口。鱼群是一定会吃料的,需要的只是一点耐心。在这个过程中,也建议外用应激解毒灵,以促进开口。
05 使用颗粒料没办法大量拌药怎么办?
建议准备几包膨化料,将膨化料充分拌药后与少量的颗粒料混合,再用投料机用最慢的速度一直投喂。
06 需要使用外用消毒、杀虫处理吗?
外用处理,绝对不能使用杀虫药,越杀只会越严重。消毒是有帮助的,可以使用沐菌消加上菌霉净(双菌组合)进行处理。

☝药敏试验表明双菌组合有协同增效作用
这个问题的关键,在于内服,强力的内服,快速促进代谢!!!
开春阶段原本就是鱼体最虚弱的时候,现在草鱼大范围的问题也是一个强烈的信号。毕竟如果是华中地区,4-5月份往后才是鱼病的高发期,现在就出现恶性问题,那么届时的情形会更不容乐观。还是早做打算的好…
乱世宜重典,急病须猛药!
努力帮自己的鱼一把,它就活下来了!每个区域都可以验证,这个问题越拖死亡越狠,越拖治疗起来越困难!
来源:王明闯